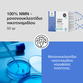
Image preview 2

αγορών είναι άδειο!



Αυτός ο ιστότοπος χρησιμοποιεί cookies για να βελτιώσει την εμπειρία σας ως χρήστη και να σας παρέχει περιεχόμενο. Ορισμένα είναι απαραίτητα για τη σωστή λειτουργία του ιστότοπου, ενώ άλλα είναι προαιρετικά. Περισσότερα πληροφορίες

Το μονονουκλεοτίδιο νικοτιναμιδίου ή NMN είναι ιδιαίτερα καθαρισμένη χημική ουσία, έτοιμη για χρήση σε ερευνητικά εργαστήρια.
Διατίθεται ως λεπτή σκόνη ομοιόμορφης ποιότητας, γεγονός που εξασφαλίζει αξιόπιστα αποτελέσματα.
Λόγω της καθαρότητας και της σταθερότητάς του, οι ερευνητές το επιλέγουν συχνά ως δοκιμασμένο υλικό για διάφορες αναλύσεις και τεστ.
Το νικοτιναμιδικό μονονουκλεοτίδιο (NMN) της μάρκας Healthy World διαθέτει καθαρότητα 100%, χωρίς καμία πρόσθετη ουσία. Ακριβώς λόγω της υψηλής καθαρότητάς του παρουσιάζει και εξαιρετική σταθερότητα.
Συστατικά: 100% μονονουκλεοτίδιο νικοτιναμιδίου - NMN (CAS 1094-61-7).
Καθαρό βάρος: 50 γρ
Προειδοποίηση: Το NMN (μονονουκλεοτίδιο νικοτιναμιδίου) είναι μια πρώτη ύλη που σύμφωνα με την ευρωπαϊκή νομοθεσία δεν είναι κατάλληλη για κατανάλωση. Προορίζεται αποκλειστικά για βιομηχανική και επαγγελματική χρήση.
Να φυλάσσεται προστατευμένο από το φως και την υγρασία, σε θερμοκρασία έως 25 °C.
Δευτέρα- Πέμπτη: 9.00 - 15.00
Παρασκευή: 9.00 - 13.00
Δυνατότητα πληρωμής με κάρτα. Εγγυημένη προστασία των προσωπικών σας δεδομένων μέσω κρυπτογράφησης SSL.
Δυνατότητα πληρωμής με κάρτα. Εγγυημένη προστασία των προσωπικών σας δεδομένων μέσω κρυπτογράφησης SSL.